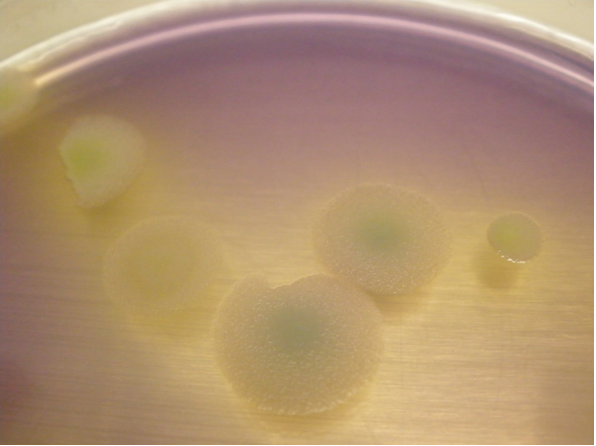

DEXTROSE TRYPTONE AGAR (DTA) (BASE) Detección de esporulados termófilos (ICUMSA, NCA) y demás Bacillus, Bacillus cereus (ISO 7932)
COMPOSICIÓN
Extracto de levadura 1,500 g
Triptona 10,000 g
Glucosa 10,000 g
Cloruro sódico 5,000 g
Púrpura de bromocresol 0,015 g
Agar-Agar 12,000 g
(Fórmula por litro)
pH final: 7,0 ± 0,2
PREPARACIÓN
Disolver 38’5 g de medio en 1 litro de agua bidestilada. Calentar hasta ebullición, agitando hasta la completa homogeneización. Autoclavar a 121 ºC durante 15 minutos.
Para que el medio sea selectivo, añadir asépticamente 10 ml/l de Polimixina B estéril (SMS009).
PARA USO EXCLUSIVO EN LABORATORIO MANTENGA EL BOTE BIEN CERRADO
EN LUGAR SECO, FRESCO Y OSCURO. AGITE EL BOTE ANTES DE USAR.
DESHIDRATADO CODIGO: DMT183
CONTROL DE CALIDAD DEL MEDIO
Realizado en nuestro laboratorio; es prudente repetirlo en su laboratorio siempre que varíen las condiciones (más de 3 meses sin usar, tras desinfectar laboratorio, tras conservar a alta Tª, cuando adquiere aspectos extraños aunque no haya llegado la fecha de caducidad teórica de la etiqueta,…)
DESHIDRATADO: Polvo fino, Verdoso PREPARADO: Estéril, Violeta
CONTROL DE CRECIMIENTO 24-48 h a 30-37°C aproximadamente:
- Bacillus cereus MKTA 10876, Excelente, colonias expandidas con intensa
acidificación del medio (viraje a amarillo). Con respecto a PCA
estandarizado*, recuento medio 218 %. - Bacillus subtilis MKTA 6633, Excelente, colonias expandidas sin acidificación
del medio (sin viraje). Con respecto a PCA estandarizado*, recuento medio
223 %. - Staphylococcus aureus MKTA 6538P, Crece, colonias redondas y discretas.
Con respecto a PCA estandarizado*, recuento medio 75 %. - Pseudomonas aeruginosa MKTA 27853, Inhibido.
- Escherichia coli MKTA 25922, Inhibido.
* El que cumple con recuperación superior al 92-125% con respecto a cepas cuantitativas
trazables a cepa tipo.
PRESENTACION: TUBOS PREPARADOS INCLINADOS, FRASCOS 100 ml, MEDIO DESHIDRATADO.
Medio para la detección de esporulados termófilos acidificantes en alimentos, incluido Bacillus coagulans. Y para detección y recuento de esporulados aerobios del aire, de las superficies y de otras muestras.
SIEMBRA
Para aerobios esporulados, a fin de germinar las esporas, calentar el tubo con dilución madre y el de dilución –1 en un baño a 80ºC durante un minuto exacto, sacar y poner en un baño de agua con hielo durante 1 hora.
Sembrar 0,1 ml de la muestra y su serie de diluciones decimales en superficie de placas duplicadas; o bien sembrar en estría en los tubos inclinados.
O bien sembrar por impacto en placa de contacto con un muestreador tipo MICROFLOW. Incubar 2-3 días a 30 ºC aproximadamente, o bien 36-48 horas a 55 ºC aproximadamente en un incubador húmedo para prevenir la desecación del medio.
Para detectar también la población de cepas termófilas puede ser necesario realizar un duplicado, e incubarlo tras darle a la placa sembrada un shock térmico de 1-4 horas a 55°C aproximadamente.
Para confirmar B.cereus, según Norma ISO 7932, incubar sólo 24 h a 30°C aproximadamente y observar el viraje del medio lila a amarillo.
INTERPRETACIÓN
B. coagulans forma colonias en “flat sour” amarillo-verdosas.
B.cereus crece en sólo 24 horas a 30°C con colonias amarillas que viran el medio a amarillo.
La mayoría de especies de Bacillus crecen selectivamente en este medio. Use KUS700 para identificar la especie de acuerdo con el Manual Berggey.
El usuario es el único responsable de la eliminación de los microorganismos según la legislación medioambiental vigente. Autoclavar antes de desechar a la basura.
Si desea más información sobre nuestros MEDIO DEXTROSE TRYPTONE AGAR (DTA) rellene nuestro formulario de contacto http://www.medioscultivo.com/contacto . O si lo prefiere póngase en contacto con nosotros a través de nuestro correo electrónico microkit@microkit.es o por teléfono en el nº 91-897 46 16
https://www.microkit.es/fichas/DEXTROSA-TRIPTONA-AGAR-DTA-BACILLUS.pdf